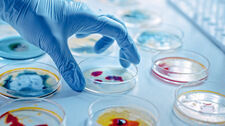
Bakterie oporne na antybiotyki? Ten elektroniczny test wykrywa to błyskawicznie

Astronomowie dostrzegli czarną dziurę. Poznali ją po kształcie gwiazdy
Po raz pierwszy zastosowano nową metodę wykrywania czarnych dziur. Astronomowie dostrzegli niewielki obiekt poza Drogą Mleczną, obserwując jego wpływ na ruch pobliskiej gwiazdy. Siła grawitacji czarnych dziur jest tak duża, że nie może z nich uciec nawet światło i są one ciemnymi pustkami niemal...